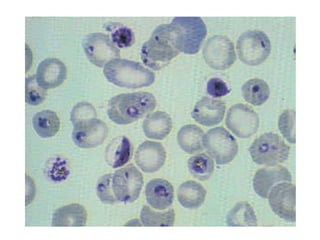

1) O documento descreve os principais filos do reino Protista, incluindo os protozoários e seus modos de reprodução e nutrição.
2) Também resume as características e doenças causadas por importantes parasitas como Trypanosoma cruzi, Plasmodium spp., Schistosoma spp. e Ascaris lumbricoides.
3) Fornece informações sobre a prevenção e controle dessas doenças parasitárias.